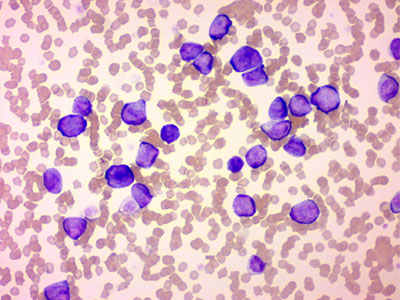

犬 血液塗抹

メルカリ 犬と猫の血液塗抹観察法 その他 2 180 中古や未使用のフリマ
院長のブログ 血液検査 岡本動物病院 島根県松江市

山陽動物医療センター 症例 血液内科 腫瘍科 皮膚科 血液病 貧血
犬 血液塗抹 のギャラリー

16 血液塗抹 犬3blood Smear Dog 15 Youtube

血液内科 彩の森動物病院 狭山市 入間市 所沢市 飯能市 川越市

研究紹介 鹿児島大学共同獣医学部 臨床獣医学講座伴侶動物内科学分野

こんなところで証拠を 免疫介在性溶血性貧血 風の動物病院のブログ

獣医学科イベント 8 17 Sat オープンキャンパス オープンキャンパス 進学相談会19 日本獣医生命科学大学

京都府 ひとみ動物病院 わんポイントレッスン 学術資料 Horiba Medical For Vet

緑書房 獣医 動物看護 犬と猫の血液アトラス

症例報告

抗血栓療法に対するcurativeガイドライン すわ動物病院
大阪府 ごんた動物病院 わんポイントレッスン 学術資料 Horiba Medical For Vet

血液塗抹ガイド ご利用の手引き 検査サービス 動物医療webサイト 富士フイルムvetシステムズ株式会社

血液内科 あさか台動物病院 朝霞市 動物病院

血液検査 白血球について 淀川中央動物病院

血液塗末標本のいろは 血液学のいろは Eduward Press Channel

血液内科 クラーク動物病院 八王子市 町田市 日野市 多摩市

購入特典動画を一部公開 血液塗抹テキスト 犬と猫の血液塗抹観察法 Youtube

マダニから感染するバベシア症 アミール動物病院 動物病院 犬 猫 フード 高知市 朝倉

緑書房 獣医 動物看護 犬と猫の血液アトラス

犬と猫の血液アトラス 石田 卓夫 本 通販 Amazon

ペットクリニックハレルヤ 動物病院 福岡
Http Www Samt Or Jp Samt Wp Content Uploads 18 11 6c4a5dc3eed58b75b16ee2bd9d1a79 Pdf

Jsfm Japanese Society Of Feline Medicine Jsfm ねこ医学会

症例報告

血液塗沫標本作りました 動物看護師のタマゴたち 動物 専門学校 大阪eco動物海洋専門学校 大阪エコ

ポイント解説 犬と猫の尿 血液検査マニュアル 猫好きが読んだ千冊の本

美味しいだけじゃない 玉ねぎの恐怖 滋賀県栗東市 野洲市 草津市の動物病院 こにし動物クリニック

免疫介在性溶血性貧血 診療科目 ふく動物病院 国立市 府中市 国分寺市 立川市

ペットクリニックハレルヤ 動物病院 福岡

血球との対話 すわ動物病院

症例報告

山陽動物医療センター 症例 血液内科 腫瘍科 皮膚科 血液病 貧血

犬と猫の血液学 キソのキソからやさしく解説 As Books 久末正晴 本 通販 Amazon
Vsj Books Posts Facebook

血液内科 北海道大学動物医療センター

山陽動物医療センター 症例 血液内科 腫瘍科 皮膚科 血液病 貧血

血液検査 白血球について 淀川中央動物病院
Http Www Jvcs Jp Pdf 17drishizakicopyright Pdf

犬のバベシア症 症状 原因から治療 予防法まで寄生虫症を知る 子犬のへや

犬に多い血液の病気 真駒内どうぶつ病院 札幌 動物病院 予約制 血液 腫瘍 がん

動画でみる猫の血液検査入門 2 末梢血液塗抹標本の作成 Youtube

大阪府 ごんた動物病院 わんポイントレッスン 学術資料 Horiba Medical For Vet

京都府 セナ動物病院 わんポイントレッスン 学術資料 Horiba Medical For Vet

山陽動物医療センター 症例 血液内科 腫瘍科 皮膚科 血液病 貧血

血液塗抹は染色法により核 染色質 顆粒の染色性で分類する 感染症の病理学的考え方
Http Www Jvcs Jp Pdf 17drishizakicopyright Pdf

こんなところで証拠を 免疫介在性溶血性貧血 風の動物病院のブログ

動物看護専門誌 As アズ 19年4月号 特集 シチュエーション別 犬の行動学をふまえた保定術 本 通販 Amazon

血液内科 あさか台動物病院 朝霞市 動物病院
のぞいてみれば12 顕微鏡をみることを好みます

犬のバベシア症 なのか 徳島県藍住町 おおしま動物病院

血液内科 北海道大学動物医療センター

緑書房 獣医 動物看護 犬と猫の血液アトラス

血液塗抹ガイド ご利用の手引き 検査サービス 動物医療webサイト 富士フイルムvetシステムズ株式会社

山陽動物医療センター 症例 血液内科 腫瘍科 皮膚科 血液病 貧血

アイツの凄いところ 愛知県瀬戸市の瀬戸健滉動物病院 犬猫のトリミング ペットホテル

血液内科 あさか台動物病院 朝霞市 動物病院
Vsj Books 犬と猫の血液塗抹観察法 ご注文フォーム Facebook
Http Www Jvcs Jp Pdf 17drishizakicopyright Pdf

ペットクリニックハレルヤ 動物病院 福岡

メルカリ 犬と猫の血液塗抹観察法 その他 2 180 中古や未使用のフリマ

犬のバベシア症 なのか 徳島県藍住町 おおしま動物病院

血液塗抹ガイド ご利用の手引き 検査サービス 動物医療webサイト 富士フイルムvetシステムズ株式会社

血液塗抹ガイド ご利用の手引き 検査サービス 動物医療webサイト 富士フイルムvetシステムズ株式会社
Http Www Jvcs Jp Pdf 17drishizakicopyright Pdf

研究紹介 鹿児島大学共同獣医学部 臨床獣医学講座伴侶動物内科学分野

No 1121 イヌの肝臓
骨髄検査 愛知県 一宮市の動物病院 ふるはし動物病院 症例集

バベシア症

血液塗抹ガイド ご利用の手引き 検査サービス 動物医療webサイト 富士フイルムvetシステムズ株式会社

犬に多い血液の病気 真駒内どうぶつ病院 札幌 動物病院 予約制 血液 腫瘍 がん

大阪府 ごんた動物病院 わんポイントレッスン 学術資料 Horiba Medical For Vet

血液内科 北海道大学動物医療センター

症例報告

ネットで形態 血液形態自習塾 第2部 末梢血 骨髄像の見方 考え方 ベックマン コールター

子犬 子猫科 Pediatrics やすだ動物病院 八戸市 犬猫小動物の病院

実習風景 動物看護師のタマゴたち 動物 専門学校 大阪eco動物海洋専門学校 大阪エコ

第1回 臨床病理学セミナー開催 血液塗抹を チーム で実践する方法 ワンちゃんの健康第一主義
Http Www Jvcs Jp Pdf Kyouikukouen a 1rinnsyoubouri Pdf

急な内出血の原因は とある薬と血小板減少症 風の動物病院のブログ

バベシア症について みんなのどうぶつ病院の診察日記

Case52 脾臓摘出を行った特発性血小板減少性紫斑病 Itp の犬の1例 つつじヶ丘動物病院 東京都調布市の動物総合病院 一般診療 循環器科 腫瘍科など
Vsj College 小笠原 聖悟 先生執筆 血液塗抹の新しいテキスト 犬と猫の血液塗抹観察法 Facebook

研究紹介 鹿児島大学共同獣医学部 臨床獣医学講座伴侶動物内科学分野

Case52 脾臓摘出を行った特発性血小板減少性紫斑病 Itp の犬の1例 つつじヶ丘動物病院 東京都調布市の動物総合病院 一般診療 循環器科 腫瘍科など

研究紹介 鹿児島大学共同獣医学部 臨床獣医学講座伴侶動物内科学分野

山陽動物医療センター 症例 血液内科 腫瘍科 皮膚科 血液病 貧血

緑書房 獣医 動物看護 犬と猫の血液アトラス
Vsj Books Posts Facebook

犬に多い血液の病気 真駒内どうぶつ病院 札幌 動物病院 予約制 血液 腫瘍 がん

血液塗抹と染色の授業を行いました 河原アイペットワールド専門学校

犬に多い血液の病気 真駒内どうぶつ病院 札幌 動物病院 予約制 血液 腫瘍 がん

血液内科 あさか台動物病院 朝霞市 動物病院

バベシア症 すざき動物病院

獣医師クイズ 臨床病理科クイズ5 Vetpedia

症例報告

犬に多い血液の病気 真駒内どうぶつ病院 札幌 動物病院 予約制 血液 腫瘍 がん

山陽動物医療センター 症例 血液内科 腫瘍科 皮膚科 血液病 貧血